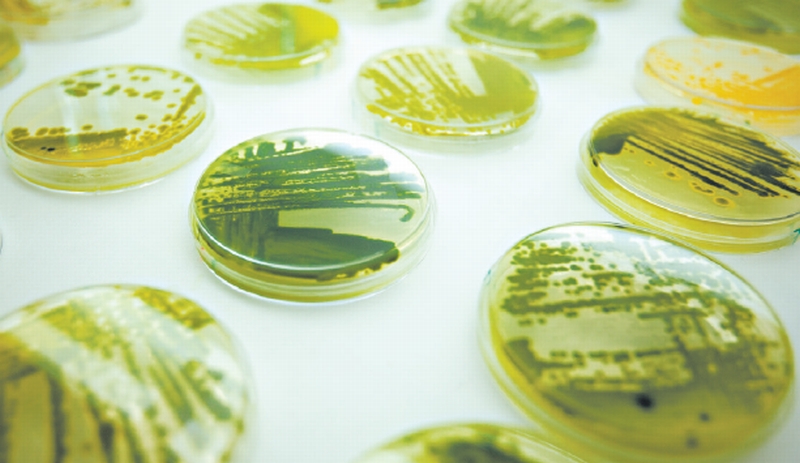

Produtos de varejo contendo ingredientes fabricados com o uso de uma técnica avançada de engenharia, conhecida por biologia sintética, começam a aparecer nas prateleiras das lojas.
Um detergente líquido para lavar roupas da Ecover, empresa belga, contém um óleo produzido por algas cujo código genético foi alterado com a aplicação da biologia sintética. A sequência de DNA da alga foi alterada em laboratório, segundo Tom Domen, gerente da Ecover. A empresa classifica o óleo à base de algas como um substituto "natural" para o óleo de palmiste.
A biologia sintética, destinada originalmente à produção de biocombustíveis, existe há 20 anos, mas só recentemente passou a ser usada em segmentos como cosméticos, sabores e fragrâncias.
A Unilever anunciou pouco tempo atrás que estava usando óleo de algas de uma empresa chamada Solazyme na composição do seu popular sabonete Lux. Mas, em um exemplo de como as empresas podem estar receosas em divulgar o uso da biologia sintética, não está claro se o óleo no Lux foi criado a partir de um processo sintético.
A Solazyme revela que usa substâncias como o coalho, empregado também na fabricação de queijos e que requer uma enzima chamada quimosina. Os estômagos de bezerros eram normalmente utilizados para a obtenção dessa enzima. Mas, desde o final dos anos 1990, a quimosina tem sido gerada por um micróbio cujo código genético foi alterado com a inserção de um gene bovino. Esse processo é o mais utilizado nos EUA.
Mas a biologia sintética envolve técnicas que alteram o código genético de forma mais ampla. Entre elas, a "síntese de genes artificial" na qual o DNA é criado em computadores e inserido em organismos e outros métodos de mudança das sequências de DNA e dos genes para alterar suas funções. Tais técnicas são usadas para induzir bactérias, fungos e outros organismos a produzir substâncias que eles normalmente não produzem.
De acordo com o ETC Group, organização que estuda novas tecnologias, a Ecover é a única companhia que confirma publicamente o uso da biologia sintética para criar um ingrediente de um produto específico, seu detergente Ecover Natural Laundry Liquid.
A Ecover compra o óleo de algas da Solazyme, que antes se apresentava como uma empresa de biologia sintética, mas retirou o termo de seu site. A Solazyme descreve o organismo que produz o óleo como "uma cepa otimizada" de algas unicelulares "que existem há mais tempo do que nós".
"Usamos a biologia molecular e a fermentação industrial para produzir óleos de algas renováveis e sustentáveis, que ajudam a aliviar a pressão sobre os frágeis ecossistemas próximos à linha do equador", disse Jill Johnson, diretor de sustentabilidade da empresa.
Ambientalistas e grupos de consumidores, no entanto, querem que a Ecover informe o uso da biologia sintética em seu novo óleo. Os grupos reconhecem que o óleo Solazyme em si não contém ingredientes geneticamente modificados no significado convencional do termo. Na verdade, o organismo que produz o óleo é que foi alterado geneticamente.
Mas eles argumentam que etiquetar produtos que contêm tais ingredientes como "naturais" dá uma falsa impressão.
Atualmente, esse mercado está desregulado. Um comitê científico da Convenção sobre Diversidade Biológica da ONU deve discutir esse florescente campo científico e as potenciais implicações regulatórias em um encontro neste mês.
Domen disse que já houve um debate interno sobre o uso do óleo de algas, mas que os benefícios ambientais se sobrepõem às preocupações sobre qualquer reação negativa dos consumidores.
A Ecover diz que está trabalhando "para identificar a melhor forma de passar essa informação" na rotulagem de seu detergente.
Colaborou Andrew Pollack



